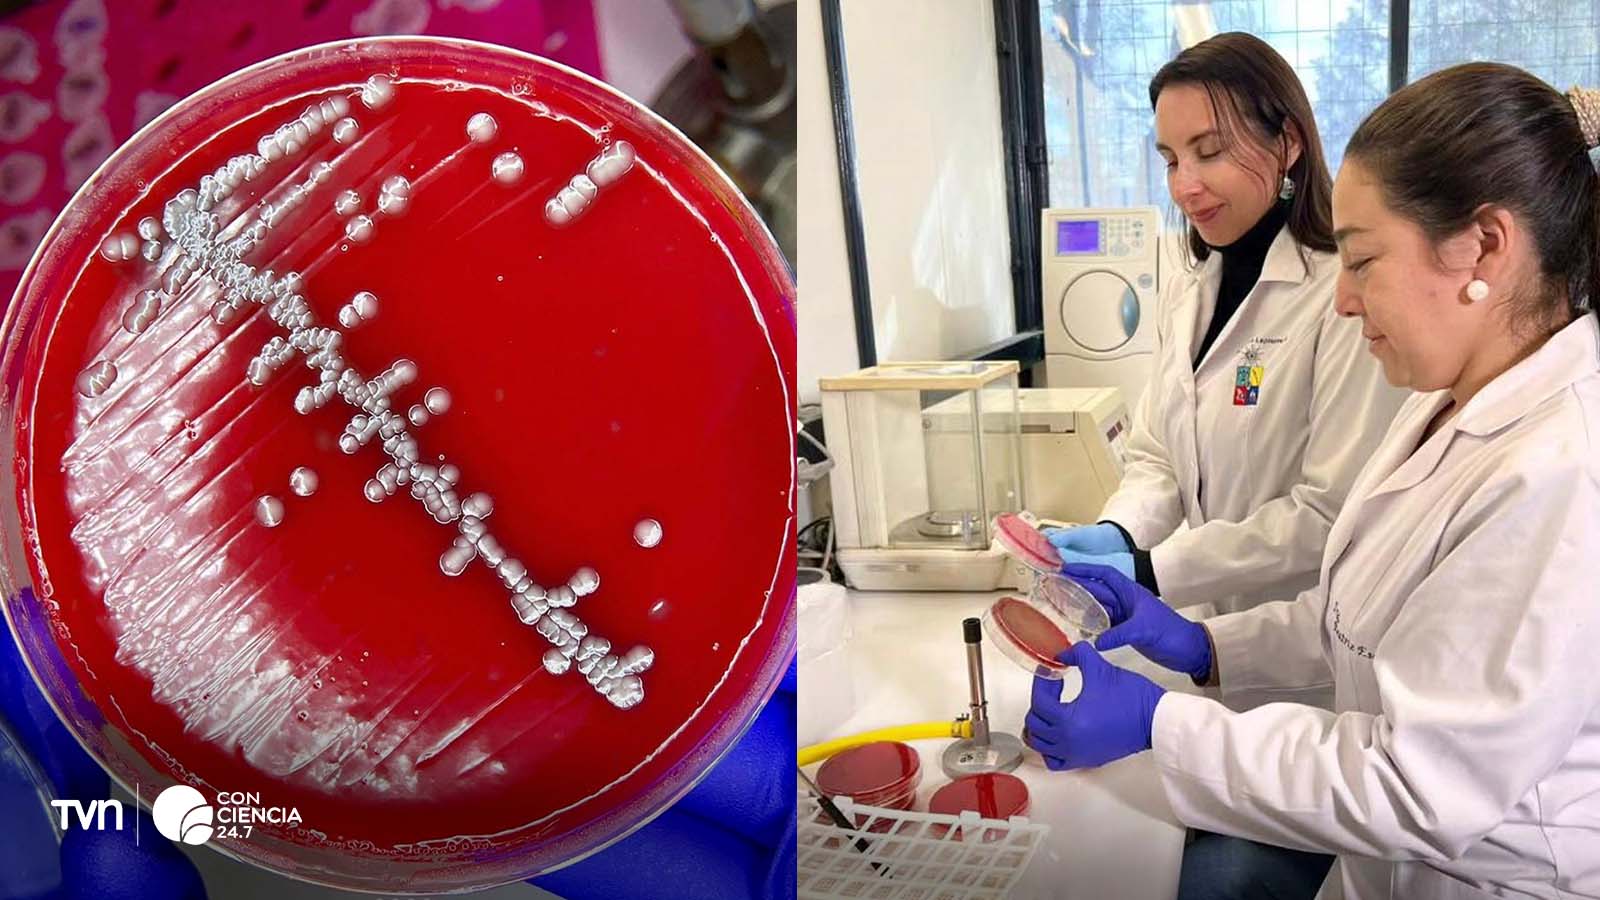

Una investigación de la Universidad de Chile encendió una alerta sanitaria: los perros domésticos sanos pueden portar y transmitir bacterias resistentes a los antibióticos utilizados en medicina humana. El hallazgo, publicado en la revista Animals, evidencia la necesidad de regular el uso de antimicrobianos en clínicas veterinarias y criaderos.
LEE TAMBIÉN EN CONCIENCIA 24.7:
- Reportaje de 24 Horas es finalista del Premio Pfizer de Periodismo en Salud 2025
- Científicos descubren dos nuevas especies fósiles en la Región de Atacama y nombran una en honor a "Chainsaw Man"
- Descubren fósil de helecho que habitó la Antártica durante la era de los dinosaurios
El estudio fue liderado por la profesora Lisette Lapierre, académica de la Facultad de Ciencias Veterinarias y Pecuarias (FAVET), junto a un equipo de investigadores conformado por Carlos Alejandro Zelaya, Gabriel Arriagada, Rosario Medina, Beatriz Escobar, Fernando Sánchez y Nicolás Galarce, con financiamiento del proyecto Fondecyt N°1210692.

“Casi uno de cada cinco perros analizados portaba cepas de Escherichia coli resistentes a antibióticos de uso crítico en salud humana”, explicó la profesora Lapierre, del Departamento de Medicina Preventiva Animal de FAVET.
Riesgos invisibles en clínicas veterinarias y criaderos
Los investigadores analizaron muestras fecales de 263 perros sanos de distintas comunas de la Región Metropolitana y detectaron una serie de factores de riesgo y protección.
Los perros hospitalizados en clínicas veterinarias tenían cuatro veces más probabilidades de portar bacterias resistentes, mientras que aquellos comprados en tiendas o criaderos presentaban seis veces más riesgo que los adoptados.
“En algunos criaderos se administran antibióticos preventivos a cachorros que ni siquiera están enfermos, solamente para asegurar su venta. Pero eso puede seleccionar bacterias resistentes que luego llegan al hogar y se transmiten a las personas”, advirtió Lapierre.
El estudio ya ha despertado interés en el Ministerio de Salud, que busca integrar esta evidencia en futuras políticas sobre uso de antimicrobianos en animales de compañía y en bioseguridad veterinaria.
Factores protectores: educación y contacto social
El equipo también identificó factores protectores sorprendentes. Los perros que convivían con personas del área de la salud mostraron menor presencia de bacterias resistentes, probablemente por mejores hábitos de higiene y uso racional de antibióticos.
Además, los perros que socializaban con otros animales, por ejemplo, en paseos o parques; también mostraron menor resistencia bacteriana.
“Creemos que la exposición a distintas bacterias puede diversificar la microbiota y reducir la presencia de cepas resistentes, aunque esto requiere más investigación”, señaló la académica.
Una salud, un desafío
La profesora Lapierre enfatizó que la resistencia a los antimicrobianos es uno de los mayores desafíos sanitarios del siglo XXI, y que debe enfrentarse bajo el enfoque Una Salud (One Health), que integra la salud humana, animal y ambiental.
“Si seguimos usando antibióticos sin diagnóstico ni control, llegará un momento en que no tendremos medicamentos eficaces ni para humanos ni para animales”, advirtió.
El estudio concluye que una tenencia responsable y una regulación más estricta del uso de antimicrobianos en la práctica veterinaria son clave para frenar la propagación de bacterias resistentes.
“No se trata de tener miedo a los animales, sino de asumir que vivimos conectados. La salud de ellos es también la nuestra”, cerró Lapierre.